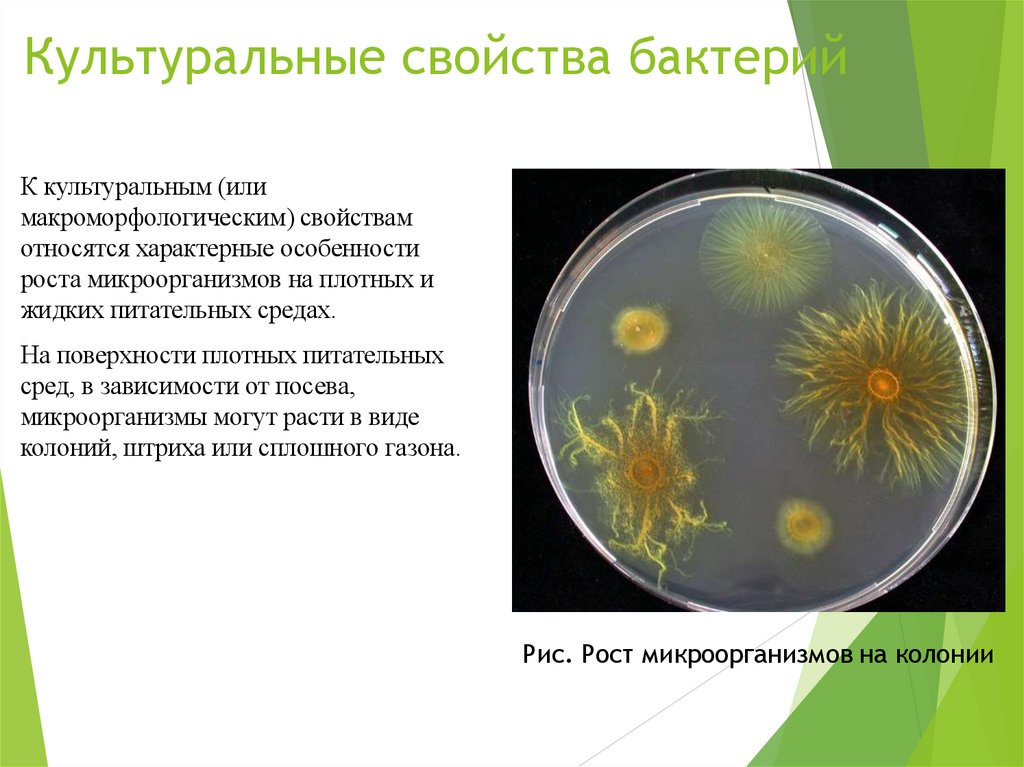
Культуральные свойства бактерий

Similar presentations:
Физиология микроорганизмов. Важнейшие микробиологические процессы
1.
Тема 1.3 Физиологиямикроорганизмов.
Важнейшие
микробиологические процессы
2. Химический состав бактериальной клетки
Важнейшими элементами бактериальной клетки являются органогены(углерод, водород, кислород, азот), которые используются для построения
сложных органических веществ: белков, углеводов и липидов.
Микроорганизмы содержат также зольные или минеральные элементы. В
количественном отношении самым значительным компонентом клетки
является вода, которая составляет 75 - 85%.
Белки (около 2000) = 40-80% (сухой массы)
*Протеины – простые белки
*Протеиды – сложные белки(нуклеопротеиды, липопротеиды,
гликопротеиды)
*Большая часть белков- ферменты
Углеводы = 30-50% (сухой массы) – полисахариды, и углеводы
Липиды = 1,7-40% (сухой массы)(фосфолипиды, жирные кислоты и
глицериды)
3. Ферменты бактерий
Ферменты – биологические катализаторы, высокомолекулярные веществабелковой природы, вырабатываемые живой клеткой. Они строго специфичны и
играют важнейшую роль в обмене веществ микроорганизмов.
*Эндоферменты и экзоферменты
Экзоферменты-выделяясь во внешнюю среду, расщепляют макромолекулы
питательных веществ до более простых соединений, которые могут быть усвоены
микробной клеткой. (Экзоферменты
гидролиза вызывают гидролиз жиров,
белков, углеводов)
Эндоферменты- участвуют в реакции обмена веществ, происходящих внутри
клетки.
Практическое использования ферментативных свойств микробов: процессы
брожения, грибы в пивоварении и виноделии, обработка шкур, для смягчения :
консервирование.
С помощью ферментов получают:
гормоны
витамины
4. Ферменты разделяют на шесть классов:
Оксидоредуктазы—
ферменты,
катализирующие
окислительновосстановительные реакции. Играют большую роль в процессах биологического
получения энергии.
Трансферазы — ферменты, катализирующие перенос отдельных радикалов,
частей молекул или целых атомных группировок (не водорода) от одних
соединений к другим.
Гидролазы — ферменты, катализирующие реакции расщепления и синтеза таких
сложных соединений, как белки, жиры и углеводы, с участием воды.
Лиазы — ферменты, катализирующие отщепление от субстратов определенных
химических групп с образованием двойных связей или присоединение отдельных
групп или радикалов по двойным связям.
Изомеразы — ферменты, осуществляющие превращение органических
соединений в их изомеры. Изомеризации подвергаются углеводы и их
производные, органические кислоты, аминокислоты и т. д. Ферменты этой
группы играют большую роль в ряде процессов метаболизма.
Лигазы — ферменты, катализирующие синтез сложных органических соединений
из простых.
Большое
число
разнообразных
ферментов,
синтезируемых
клетками
микроорганизмов, позволяет использовать их в промышленном производстве для
приготовления уксусной, молочной, щавелевой, лимонной кислот, молочных
продуктов (сыр, ацидофилин, кумыс), в виноделии, пивоварении, силосовании.
5. МЕТАБОЛИЗМ
Все реакции жизнеобеспечения, происходящиев микробной клетке и катализируемые
ферментами, составляют обмен веществ, или
метаболизм.
Промежуточные
или конечные продукты,
образующиеся
в
соответствующей
последовательности ферментативных реакций,
в результате которых разрушается или
синтезируется ковалентно связанный скелет
конкретной
биомолекулы,
называют
метаболитами.
6. Питание бактерий
По способности усваивать азот микроорганизмы делят на 2 группы: аминоавтотрофы иаминогетеротрофы
Аминоавтоторофы- для синтеза белка клетки используют молекулярный азот воздуха или
усваивают его из аммонийных солей.
Аминогетеротрофы- получают азот из
органических соединений- аминокислот, сложных
белков. Сюда относятся все патогенные микроорганизмы и большинство сапрофитов.
7. Дыхание бактерий
Дыхание - это сложный процесс, который сопровождаетсявыделением энергии, необходимой микроорганизмам для синтеза
различных органических соединений. Все бактерии по типу дыхания
подразделяются на облигатные аэробы, микроаэрофилы,
факультативные анаэробы, облигатные анаэробы.
Бактерии, нуждающиеся в свободном кислороде , называются
аэробными, а те, которые могут без него обойтись, - анаэробными.
Облигатные(строгие) аэробы развиваются при наличии в атмосфере
20 % кислорода(микобактерии туберкулеза), содержат ферменты, с
помощью которых осуществляется перенос водорода от окисляемого
субстрата к кислороду воздуха.
Микроаэрофилы нуждаются в значительно меньшем количестве
кислорода, и его высокая концентрация хотя и не убивает бактерии,
но задерживает их рост(актиномицеты, лептоспиры)
Факультативные анаэробы могут размножаться как в присутствии,
так и в отсутствии кислорода(большинство патогенных и
сапрофитных микробов- возбудители брюшного тифа, паратифов,
кишечная палочка)
Облигатные анаэробы – бактерии, для которых наличие
молекулярного кислорода является губительным(клостридии
столбняка, ботулизма).
8. РОСТ И РАЗМНОЖЕНИЕ БАКТЕРИЙ
Термин«рост»
означает
увеличение
цитоплазматической массы отдельной клетки или
группы бактерий в результате синтеза клеточного
материала
(например,
белка,
РНК,
ДНК).
Достигнув
определенных
размеров,
клетка
прекращает рост и начинает размножаться.
Под
размножением микробов подразумевают
способность
их
к
самовоспроизведению,
увеличению количества особей на единицу
объема. Иначе можно сказать: размножение — это
повышение числа особей микробной популяции.
9. Фазы развития бактериальной популяции
Общую закономерность роста и размножениябактериальной популяции принято показывать
графически в виде кривой, которая отражает
зависимость логарифма числа живых клеток
от времени.
Типичная кривая роста имеет S-образную
форму и позволяет различать несколько фаз
роста, сменяющих друг друга в определенной
последовательности.
10.
Описать фазы роста (см вложение документ ворд)11. Питательные среды. Их значения, применения, классификация.
Питательной средой в микробиологии называют среды, содержащие различныесоединения сложного или простого состава, которые применяются для размножения
бактерий или других микроорганизмов в лабораторных или промышленных условиях.
Предложено очень большое количество сред, в основе классификации которых
положены следующие признаки:
1. По исходным компонентам различают натуральные и синтетические среды.
НАТУРАЛЬНЫЕ
СРЕДЫ- готовят из
продуктов
животного и
растительного
происхождения.
СИНТЕТИЧЕСКИЕготовят из органических
и неорганических
соединений, взятых в
точно указанных
концентрациях и
растительных в дважды
дистиллированной
воде.
12. Различают по: 1. консистенции:
ЖидкиеПолужидкие
Плотные
Плотность достигается за счет
добавления агара или
желатина
2. составу:
Простые (МПА, бульон, агар Хоттингера, желатин, пептон, Н2О)
Сложные (простые среды+кровь, сыворотка, углеводы и др)
13. 3. назначению:
А) Основные, они служат для культивированиябольшинства патогенных микробов. К ним
относят: МПБ, МПА, бульон и агар, пептонная
вода.
Б) Специальные сред служат для выделения и
выращивания микроорганизмов, не
расщепляющих на простых средах.
В) Элективные (избирательные)
благоприятствующие росту определенного вида,
подавляющий рост других.
Г) Дифференциально-диагностические среды
позволяют отличить один вид микроба от другого
по ферментативной активности.
Д) Консервирующие среды предназначены для
первичного посева и транспортировке
исследования материала.
14. Условия культивирования микроорганизмов
Культивирования микроорганизмов – это выращивание их в искусственныхусловиях, обеспечивающие их интенсивное размножение.
Требования:
Правильно подобранная питательная среда;
Оптимальные условия культивирования:
Температура (по температурному оптимуму роста выделяют три основные группы
микроорганизмов:
Психрофилы- растут при температурах ниже +20 градусов Цельсия;
Мезофилы- растут в диапазоне температур от 20 до 45 градусов (часто при 37 градусах С);
Термофилы- растут при температурах выше плюс 45 градусов).
Свет
Влажность
Срок культивирования (18-24 ч)
Аэрация:
пассивная – культивирование на плотных и жидких питательных средах в сосудах с
ватно-марлевыми пробками или ч. Петри;
активная – глубинное культивирование.
15. Выделение чистой культуры бактерий
Выделение чистой культуры бактерийявляется обязательным этапом всякого
бактериологического исследования.
Чистая культура необходима для
изучения
морфологических,
культуральных,
биохимических
и
антигенных свойств, по совокупности
которых
определяется
видовая
принадлежность
исследуемого
микроорганизма.
При выделении чистой культуры
патогенных
микробов
из
патологического
материала,
загрязненного
посторонней
микрофлорой, прибегают иногда к
заражению лабораторных животных,
восприимчивых к тому виду микроба,
который предполагается выделить из
исследуемого материала.
16. Культуральные свойства бактерий
К культуральным (илимакроморфологическим) свойствам
относятся характерные особенности
роста микроорганизмов на плотных и
жидких питательных средах.
На поверхности плотных питательных
сред, в зависимости от посева,
микроорганизмы могут расти в виде
колоний, штриха или сплошного газона.
Рис. Рост микроорганизмов на колонии
17. Важнейшие микробиологические процессы. Виды брожения.
18. Спиртовое брожение
- процесс превращения углеводов в этиловый спирт и углекислый газ врезультате жизнедеятельности микроорганизмов (главным образом
дрожжей). Широко применяется в пищевой, в том числе спиртовой
промышленности.
Из чего происходит спиртовое брожение
В промышленном производстве спирта используют различные материалы:
пшеницу, рожь, ячмень, кукурузу, картофель, свеклу, древесные опилки,
солому и т.
Клетчатку соломы и древесных опилок предварительно подвергают
кисличному гидролизу, а крахмал зерновых злаков - осахариванию солодом.
19. Осахаривание
ОСАХАРИВАНИЕ, превращение в сахар полисахаридов—крахмала,целлюлозы, гликогена, инулина.
Реакция осахаривания (гидролиза) в самой общей форме может быть
выражена уравнением
(С6Н10О5)n + nН20 = nС6Н1206.
20. Спиртовое брожение
Спиртовое брожение — химическая реакция брожения, осуществляемаядрожжами, в результате которой одна молекула глюкозы преобразуется в 2
молекулы этанола и в 2 молекулы углекислого газа.
Химизм спиртового и молочнокислого брожения
21. Спиртовое брожение
Вызывается настоящими дрожжами (род сахаромицеты, вид церевизия идругие), некоторыми бактериями и грибами.
Дрожжи встречаются в воздухе, на фруктах, ягодах, в почве. Культурные
дрожжи полезны.
В зависимости от поведения и tº делятся :
a) Дрожжи верхового брожения - при доступе О2, делают субстрат
мутным, на дне – рыхлый осадок, много пены. Используется в
производстве спирта, хлебопечении;
b) Дрожжи низового брожения - при 6-10оС, дают компактный осадок. В
производстве пива, вин;
Дикие дрожжи, а также м.к.б., у.к.б. могут изменить запах, вкус вина,
вызвать скисание и ослизнение.
22. Применение спиртового брожения
сходно с применением дрожжей:пивоварение, квасоварение, приготовление дрожжевого теста, виноделие и
производство других алкогольных напитков.
23. Молочнокислое брожение
- процесс сбраживания углеводов молочнокислыми бактериями собразованием молочной кислоты. На молочнокислом брожении. основаны
приготовление молочнокислых продуктов, силосование кормов, квашение
овощей, промышленное получение молочной кислоты из крахмала.
Молочно-кислое брожение вызывается несколькими видами бактерий.
Типичные молочнокислые бактерии почти полностью превращают углеводы
в молочную кислоту без побочных продуктов, таких, как углекислота,
уксусная кислота и др. К этой группе микробов относят ацидофильную
болгарскую палочку, бактерию казеи, а также молочнокислые кокки.
24. В молоке они расщепляют
молочный сахар и превращают его в молочную кислоту, повышаюткислотность среды, и молоко свертывается, образуя плотный однородный
сгусток. Понижение температуры замедляет развитие молочнокислых
бактерий, при температуре свыше 50° они погибают, при оптимальной
температуре (20-30°) в питательной среде интенсивно накапливается
молочная кислота.
Химизм процесса
С6Н12О6 → 2СН3 - СН – СООН + 89 кДж
|
ОН
tº = 25-50ºC.
25. Молочнокислое брожение
Химизм процессаС6Н12О6 → 2СН3 - СН – СООН + 89 кДж
|
ОН
tº = 25-50ºC.
26. Молочнокислые бактерии широко распространены
в природе, они встречаются в воздухе, на поверхности животных и растений,часто попадают в молоко и вызывают его естественное скисание. Эти
бактерии подавляют развитие гнилостных микробов, кишечную и
паратифозную палочки. Поэтому молочнокислые продукты (ацидофилин,
лактобациллин, простокваша и др.) успешно используют в целях
профилактики и лечения желудочно-кишечных заболеваний.
М.к.б. делятся на:
1) Гомоферментативные - анаэробы или микроаэрофилы. Неподвижны,
не образуют спор. Нуждаются в богатой питательной среде, рН < 7,
переносят сушку. Палочковидные и кокки.
Виды:
молочнокислый стрептококк, сливочный стрептококк, болгарская,
ацидофильная и палочка Дельбрюха, молочнокислая палочка, сырная
палочка.
2) Гетероферментативные - факульт.анаэробы. Помимо молочной
кислоты образуют уксусную, этанол, янтарную.
Виды:
Капустная палочка, ароматизирующие молочно-кислые
стрептококки.
27. Молочнокислые бактерии
М.к.б. могут вызывать порчу товаров, особенно вакуумно упакованных,сбраживание соков, порчу пастеризованного молока. Некотоые (например,
ацидофильная палочка) - антагонист гнилостных бактерий в кишечнике.
Процесс силосования
Молочная кислота препятствует развитию гнилостных микробов, в
результате чего получается силос, который без доступа воздуха может
сохраняться в течение многих месяцем и даже нескольких лет. Для
повышения качества силоса рекомендуют в силосуемую массу добавлять
закваску из чистой культуры молочнокислых бактерий.
28. Процесс силосования
Молочная кислота препятствует развитию гнилостных микробов, врезультате чего получается силос, который без доступа воздуха может
сохраняться в течение многих месяцем и даже нескольких лет. Для
повышения качества силоса рекомендуют в силосуемую массу
добавлять закваску из чистой культуры молочнокислых бактерий.
29. Силосование
30. Маслянокислое брожение
- сбраживание углеводов (например, крахмала), некоторых спиртов иорганических кислот с образованием масляной кислоты, а также уксусной
кислоты, CO2 и H2; один из основных видов брожения. М. б.
осуществляется бактериями рода Клостридии, маслянокислое брожение
вызывает пороки сыра (неприятный запах, свищи), а также порчу силоса.
31. Маслянокислое брожение
Маслянокислым брожением получают масляную кислоту, обладающуюгорьким вкусом и резким запахом.
Она широко применяется в технике.
Эфиры масляной кислоты имеют приятный запах цветов или фруктов и
используются для приготовления ароматических эссенций в кондитерской
промышленности и при производстве газированных напитков, а также в
парфюмерной промышленности (например, метиловый эфир с яблочным
запахом, этиловый эфир с грушевым запахом, амиловый – с ананасным).
32. Пропионовокислое брожение
3С6Н12О6 → 4СН3СН2СООН + 2СН3СООН + 2СО2 + 2Н2О + Qtº = 14-35º Возбудители - строгие анаэробы. Способны сбраживать глицерин
и молочную кислоту - формируется рисунок сыра, вкус и запах.
Короткие неподвижные бесспоровые палочки. Некоторые образуют
витамины В12.
33. Уксуснокислое брожение
С2Н5ОН + О2 → СН3СООН+ Н2О + 740 кДж.
tº = 20-34º. Возбудители - на ягодах, фруктах. Любят кислую среду.
Виды: уксусная, орлеанская, уксуснокислая, палочка Шютценбаха.
34. Лимоннокислое брожение.
ОН│
С6Н12О6 + 3О → НООС─СН2 ─С ─СН2─СООН + 2Н2О
│
СООН
tº = 30-32ºС
Возбудители - плесневые грибы - цитромицеты, в т.ч. аспергиллус нигер.
Метод Костычева и Буткевича:
на питательной среде (сахар + соли, tº = 30-32º С, в течение 2х дней вырастает
складчатая пленка гриба. Затем питательный раствор сливают, промывают
кипяченой водой гриб и вводят чистый раствор сахара - через 3 – 4 дня готова
лимонная кислота.
35. Разрушение жиров
Активные разрушители жиров:Синегнойная палочка, холерный вибрион, тифозные, туберкулезные
палочки, из грибов - пенициллиум, аспергиллус, молочная плесень,
актиномицеты. Все эти м/о осуществляют гидролиз жиров.
Дальнейший распад - другие м/о, в т.ч. дрожжи, у.к.б.
Для защиты жиров - хранить при низких tо.
Гниение
В узком смысле гниение - это разложение белков под влиянием м/о.
С этой точки зрения порча древесины, овощей, фруктов - это не гниение, а
м/б заболевание.
Гниение может вызываться и аэробами, и анаэробами. 1й этап - гидролиз
(разложение белка до аминокислот).
Затем - дезамилирование, декарбоксилирование – получение летучих
пахучих веществ

biology
biology








